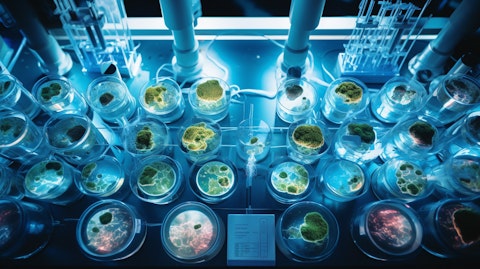
An overhead shot of a modern lab with bioengineered human tissue samples on a light table.

Humacyte, Inc. (NASDAQ:HUMA) Q3 2025 Earnings Call Transcript November 12, 2025
Humacyte, Inc. beats earnings expectations. Reported EPS is $-0.14, expectations were $-0.17.
Operator: Good morning, ladies and gentlemen, and welcome to the Humacyte’s Third Quarter Results Conference Call. [Operator Instructions] As a reminder, this conference call is being recorded. I’ll now turn the call over to Tom Johnson with LifeSci Advisors. Please go ahead.
Thomas Johnson: Thank you, operator. Before we proceed with the call, I would like to remind everyone that certain statements made during this call are forward-looking statements under U.S. federal securities laws. These statements are subject to risks and uncertainties that could cause actual results to differ materially from historical experience or present expectations. Additional information concerning factors that could cause actual results to differ from statements made on this call is contained in our periodic reports filed with the SEC. The forward-looking statements made during this call speak only as of the date hereof, and the company undertakes no obligation to update or revise the forward-looking statements, except as required by law.
Information presented on this call is contained in the press release we issued this morning and in our Form 10-Q, which after filing may be accessed from the Investor page of the Humacyte website. Joining me on today’s call from Humacyte are Dr. Laura Niklason, President and Chief Executive Officer; and Dale Sander, Chief Financial Officer and Chief Corporate Development Officer. Dr. Niklason will provide a summary of the company’s progress for the third quarter and recent weeks, and Dale will review the company’s financial results for the quarter ended September 30, 2025. I will now turn the call over to Dr. Niklason. Laura?
Laura Niklason: Thank you, Tom. Good morning, everyone, and thank you for joining us for our third quarter 2025 financial results and business update call. I’m pleased to report that our third quarter was a productive period for Humacyte and continued execution of our commercial launch with Symvess and also with advancement of our other bioengineered vessel programs. During today’s call, I’ll review progress across our commercial and development programs before turning the call over to Dale for a review of his financial — of our financial results for the third quarter. Beginning with our commercial launch of Symvess, we’re pleased by the traction we continue to gain in our interactions with surgeons and hospitals. To date, 25 hospitals and/or health care systems have completed the Value Analysis Committee, or VAC process and have approved the purchase of Symvess.
Since these VAC approvals include multi-hospital networks, approvals obtained thus far represent 92 civilian hospitals now eligible to purchase Symvess. An additional 45 VAC committees at hospitals or health systems are currently conducting reviews of Symvess. Along with the progress in VAC reviews and approvals in the third quarter, product sales improved to $703,000, a significant increase over the $100,000 that we reported last quarter. Our active engagement with surgeons and clinicians continues to grow, and we’re observing an increased number of hospitals placing orders and reordering Symvess. This active physician engagement is complemented by our steady drumbeat of strong publications that support Symvess and our technology platform.
As you know, in July, we announced that Symvess had been awarded the Electronic Catalog, or ECAT listing approval from the U.S. Defense Logistics Agency, which provides the Department of Defense and other federal agencies with access to manufacturers and distributors’ products. ECAT approval make Symvess available to health care professionals treating military service members, veterans and other patients receiving care at military treatment facilities and the U.S. Department of Veterans Affairs Hospitals. Since obtaining ECAT approval, we recorded our first commercial sale to U.S. military facilities. And we have great interest in improving medical options available to health care professionals who are treating military personnel and their families, and we look forward to advancing our discussions with additional DoD-affiliated hospitals.
Our commercial rollout of Symvess was supported by the recent publication of 3 studies demonstrating the potential of this product in vascular trauma. First, the publication entitled Bioengineered Human Blood Vessels To Treat Hospital-acquired Vascular Complications was published recently in the Journal of Vascular Surgery. This publication describes the outcomes of using Symvess in the treatment of arterial injuries that are sustained in the process of medical care rather than injuries that are sustained in the community. Complications of surgery and vascular procedures, including iatrogenic injuries, planned oncologic tumor resections and what have you, are increasingly common in modern medical care and comprise up to 30% of patients requiring vascular injury repairs.
Harvesting of autologous vein to address these consequences and complications produces additional injury for the patient and suitable vein may not always be accessible. This publication describes the outcomes of patients with hospital-acquired iatrogenic injuries or complications of vascular surgery procedures, which was a subgroup of our V005 pivotal Phase II/III clinical study that we conducted in the U.S. and Israel. At the end of an average follow-up of 23.3 months, 92% of the patients retained secondary patency or had blood flow in the conduit. None of the patients suffered an amputation, and there were 0 infections of Symvess. Patients experiencing hospital-acquired vascular complications represent an important subset of vascular trauma patients, and it’s gratifying to see that the outcomes in this study show that Symvess can provide limb salvage and durable potency.
Another publication in the Oxford Academic Journal Military Medicine described positive long-term results from our humanitarian program using Symvess to treat wartime vascular injuries in Ukraine. This publication reported on 17 patients suffering combat-related extremity vascular trauma from gunshot wounds, blasts and shrapnel. Up to 18 months — after up to 18 months of follow-up, physicians observed 0 deaths, 0 infections and 0 amputations in these treated patients in Ukraine. Furthermore, Symvess had a high potency of 87.1% and no instances of immunologic rejection. These outcomes demonstrate the long-term durability of Symvess in the treatment of real-world combat injuries. And finally, the Trauma Surgery and Acute Care Open Journal published results of a new study comparing clinical outcomes of Symvess to those resulting from autologous vein in the treatment of extremity arterial trauma.
This analysis leveraged data from 2 clinical trials, Humacyte’s Phase II/III V005 study and the humanitarian V017 study in Ukraine and match Symvess patients in those trials to patients who had suffered similar injuries and who were previously treated with vein. The matching patients who were previously treated with vein were obtained from the PROspective Observational Vascular Injury treatment, or PROOVIT registry, which is the world’s largest vascular trauma database. The comparison between Symvess and vein outcomes found that patients who were treated with Symvess had statistically similar outcomes to patients from the PROOVIT registry who received autologous vein. Secondary patency for Symvess versus the autologous vein group was 91% versus 97.7%.
The amputation rate was 7.5% versus 8.2%. The conduit infection rate was 1.5% versus 0%, and the death rate was 4.5% for both groups, respectively. There were no significant differences that were noted between the 2 groups for any of these outcomes that were assessed. The use of autologous vein to repair an injured blood vessel is the current standard of care because it offers excellent long-term patency and low infection rate. However, in many cases, suitable autologous vein may not be available due to extreme limb damage, prior surgeries or poor vein quality. Even when available, harvesting the vein is a time-consuming procedure and may not be an option for patients with severe traumatic injuries. We believe that the results of this study underscore Symvess’ potential as a much needed effective and life-saving alternative as a treatment for patients where autologous vein is not feasible.
We’re very pleased with these study results. And as Symvess is increasingly adopted by surgeons, we’re confident that we will continue to see the benefits of this product validated by further research. In addition, we have another publication of the long-term results of Symvess in vascular trauma in a civilian setting that will be forthcoming soon. I’ll turn now to the program that is our next priority, which is dialysis access. Positive 2-year results from the V007 Phase III trial of the ATEV in dialysis patients were presented last weekend at the American Society of Nephrology’s Kidney Week 2025, which is the premier nephrology meeting. The ATEV demonstrated superior duration of use over 24 months as compared to autogenous fistula in high-need subgroups that have historically poor outcomes with AV fistula procedures.
The significantly longer duration of ATEV use over 2 years in patients with this high unmet need could greatly reduce reliance on catheters for dialysis access, which are a major cause of complications, morbidity and costs for dialysis patients. Women and men with diabetes and obesity make up more than half of the dialysis access market and are historically underserved by the current standard of care. It’s been known for decades that women, in particular, suffer low rates of fistula maturation, lower rates of fistula maturation than do men, but a lack of better alternatives has limited progress for these patients. We believe that the efficacy and safety results in this subgroup, combined with the approximately 50% failure rate of fistulas in this subgroup, makes women and high-risk men an important population for Humacyte to target.
We look forward to publication of the results from the V007 Phase III trial in a major peer-reviewed medical journal. Before we file a supplemental BLA for the ATV and dialysis access, our plan is to complete a prespecified interim analysis of the currently ongoing trial, which is the V012 Phase III trial, which is being conducted in women on hemodialysis. The V012 trial compares the ATEV to women receiving fistula for hemodialysis access. A total of 109 patients have been enrolled to date in the V012 Phase III clinical trial, and an interim analysis is planned when the first 80 patients reach 1 year of follow-up, meaning that the interim analysis results should be available around April of 2026. Subject to those interim results, our plan is to submit a supplemental BLA in the second half of 2026, including data from V012, which is ongoing and the V007 Phase III pivotal study in order to add dialysis access as an indication for the ATEV.
Finally, I’ll briefly discuss one of our earlier-stage programs that we’re also very excited about, our coronary tissue engineered vessel, or CTEV, for use in coronary artery bypass grafting, or CABG. Positive results of a preclinical study evaluating the CTEV as a coronary artery bypass graft in a nonhuman primate model were published in September of 2025 in JACC Basic Translational Science, which is a specialist journal launched by the Journal of the American College of Cardiology. In this study, the CTEV was observed to sustain blood flow, recellularize with the animals host cells and remodel to bring the diameter of the CTEV in line with an animal’s native coronary artery. We are on track with our plan to advance CTEV into first-in-human study in CABG in 2026.
We have filed an IND with the FDA for the CABG indication. And if successful, the CTEV would be the first novel conduit to be tested in CABG in the U.S. in decades. Before turning the call over to Dale, I’ll mention last the expansion of our intellectual property estate and the grant of a new U.S. patent covering the composition of a bioengineered esophagus. This new patent provides protection into 2041 for key structural and mechanical attributes for an esophageal replacement, including size, strength and methods of production. Our tubular prosthesis patent family now encompasses granted claims for the composition and methods for engineered trachea, engineered urinary conduits and engineered esophagus. So our third quarter has been very productive for Humacyte as we’ve continued to grow our commercial launch and continue to publish strong supportive data for our vessel Symvess in multiple indications.
We also look forward to continuing to share our progress going forward. And with that, I’ll now turn the call over to Dale for a review of our financial results and other business developments.
Dale Sander: Thank you, Laura, and good morning, everyone. Revenue for the 3 months ended September 30, 2025, was $0.8 million, of which $0.7 million related to U.S. sales of Symvess. The remaining $0.1 million resulted from a research collaboration with a large medical technology company. Revenue for the 9 months ended September 30, 2025, was $1.6 million, of which $0.9 million related to U.S. sales of Symvess and $0.6 million resulted from the research collaboration. There was no revenue either for the 3 or 9 months ended September 30, 2024. Cost of goods sold were $0.3 million and $0.6 million for the 3 and 9 months ended September 30, 2025, respectively, which includes overhead related to unused production capacity that was recorded as an expense in the applicable periods.
There was no cost of goods sold for either the 3 or 9 months ended September 30, 2024. Research and development expenses were $17.3 million for the 3 months ended September 30, 2025, compared to $22.9 million for the prior year period and were $54.7 million for the 9 months ended September 30, 2025, compared to $67.9 million for the same period in 2024. The decrease in research and development expenses for the third quarter of 2025 compared to 2024, primarily related to the capitalization of material and overhead costs associated with the commercial manufacturing of Symvess and cost reductions implemented during the quarter ended June 30, 2025. The decrease in research and development expenses for the 9 months ended September 30, 2025, compared to 2024 resulted primarily from decreased material costs as the company began capitalizing expenditures for inventory following the commercial launch of Symvess, combined with the winding down of certain clinical trial programs, partially offset by higher noncommercial production runs.
Selling, general and administrative expenses were $7.6 million for the 3 months ended September 30, 2025, compared to $7.3 million for the prior year period and were $23.6 million for the 9 months ended September 30, 2025, compared to $18.4 million for the same period in 2024. The increase in 2025 expenses compared to the prior year periods resulted primarily from the U.S. commercial launch of Symvess in the vascular trauma indication, including increased personnel expenses. Other net income for the 3 months ended September 30, 2025, was $6.9 million compared to net expense of $9.0 million for the prior year period. And other net income was $61.3 million for the 9 months ended September 30, 2025, compared to other net expense of $41.5 million for the same period in 2024.
The increase in other net income for the 3 and 9 months ended September 30, 2025, compared to the prior year periods resulted primarily from the noncash remeasurement of the contingent earn-out liability associated with the company’s August 2021 merger with Alpha Healthcare Acquisition Corp. Net loss was $17.5 million for the 3 months ended September 30, 2025, compared to a net loss of $39.2 million for the prior year period and net loss was $16.0 million for the 9 months ended September 30, 2025, compared to a net loss of $127.8 million for the same period in 2024. The decrease in net loss for the 3 and 9 months ended September 30, 2025, compared to the prior year periods was primarily due to noncash remeasurement of the contingent earn-out liability described previously, combined with current period decreases in operating expenses and a decrease in loss from operations.
We had cash, cash equivalents and restricted cash of $19.8 million as of September 30, 2025. In addition, subsequent to September 30, 2025, we completed the sale of common stock and warrants that added an additional net proceeds to our cash position of approximately $56.5 million. As will further be discussed in the 10-Q to be filed later today, we believe that gives us cash runway exceeding 12 months from today’s date. Total net cash used in operating expenses was $78.9 million for the first 9 months of 2025 compared to cash — net cash used of $71.5 million for the first 9 months of 2024. The increase in net cash used for operating activities during the first 9 months of 2025 compared to the prior year resulted primarily from the buildup of inventory associated with the commercial launch of inventory, partially offset by our reduced loss from operations.
With that, I’ll turn the call over to Laura.
Laura Niklason: Thank you, Dale. With our strong commercial execution, our promising pipeline programs and our dedicated team, we remain committed to delivering truly transformative regenerative medicine solutions to improve patient outcomes. We believe that we are positioned for growth and value generation in the remainder of 2025 and beyond. Thank you all for joining us today. Operator, we’re now ready to take questions.
Q&A Session
Follow Humacyte Inc. (NASDAQ:HUMA)
Follow Humacyte Inc. (NASDAQ:HUMA)
Receive real-time insider trading and news alerts
Operator: [Operator Instructions] Our first question comes from the line of Matt Miksic with Barclays.
Sneha Muthe: This is Sneha on for Matt Miksic. We wanted to ask — one of the first questions we just kind of wanted to ask was, in Q2, you mentioned that 12 of the 45 hospitals had initiated the VAC process and now you said that 16 had started ordering. How many of those that have started ordering have begun the reorder process? And have you disclosed that data?
Laura Niklason: We have not disclosed that data previously, but I believe the majority have reordered.
Sneha Muthe: Okay. And then just as a quick follow-up. Now that you have this new data from the trial for 007, how does that change your view for the potential for Symvess in dialysis?
Laura Niklason: Well, we believe that the very strong results in duration of usability in these subgroups of patients with a high unmet need going out to 2 years is very, very strong data. Most studies in dialysis access have follow-up time periods of a year. So showing continued sustained benefit in these high-need subgroups going out to 2 years versus the gold standard of current care, we believe is very important. And we believe it will be a strong support when we eventually file our supplemental BLA application in dialysis access. And again, these subgroups are not small. It’s — if you combine all women with men having these risk factors, it’s more than half of the dialysis population.
Operator: Our next question comes from the line of Ryan Zimmerman with BTIG.
Iseult McMahon: Laura, this is Izzy on for Ryan. Congrats on all the progress this quarter. Just to start out on the launch that you — the progress with the launch so far. Out of the units that you’ve been purchased, I was curious what is — or how many of those have been used versus what are initial stocking orders at these hospitals?
Laura Niklason: It’s very hard to answer that question succinctly. What I can tell you and what we’ve messaged to the market before is that, initial stocking orders range from 1 to 3 units. There are a couple of hospitals who are ordering on an as-needed basis, although that’s less common. Typically, what we’re starting to see with usage and repeat usage is that, as hospitals use the vessel and then they come down to their par, then they will reorder when they hit their — when they fall below their par level, whether that’s 1 or 2 or 3 units. So we have been — again, we’ve been getting good feedback from surgeons as far as how happy they are using the product. Surgeons tell us that it’s easy to handle and that they’re pleased with its function in the OR.
I would also say, although you didn’t ask this question, that we have several presentations on the function of our vessel that are being presented at the VEITH meeting, which is the large annual vascular surgery meeting in New York every year. Those presentations are going to be coming online next week.
Iseult McMahon: That’s helpful, Laura. And I believe last quarter, you called out the fact that the price has come down for Symvess. I was curious what benefits you’ve seen from that, if it’s accelerated any of the adoption or if it even decreased the time it’s taking for these hospitals to get through their VAC approvals.
Laura Niklason: Yes and yes. Yes. The market is price sensitive now. That’s certainly true. As we’ve discussed before, in the post-COVID era, hospitals are looking much more closely at budgets. And so, the price sensitivity is something that we found to be important. With this lower price point, what we’ve seen is that, hospitals are moving through the VAC process quicker. There are some hospitals and groups of hospitals that did not consider us at our original price point. But with further discussions on price, they’ve now reinstituted the VAC process, and so that has reopened other doors. And the VAC process tends to be moving a little bit more quickly. So this is still a process that takes time. And once the VAC approvals are obtained, then there’s a 1- or 2- or 3-month contracting process that happens with each hospital. So there is a time factor here, but we’ve definitely seen an acceleration, both of VAC submissions and also an acceleration to time for approval.
Iseult McMahon: That’s helpful. And if I could squeeze in just one more for Dale. I believe you guys have called out some cost savings initiatives that have been put in place for ’25 and ’26 for about $50 million in total savings. I was curious if you’re still feeling comfortable with this level or if we should expect any changes as we start to think about next year. Congrats again on the progress.
Dale Sander: Thanks, Izzy. And no, absolutely, we are seeing those savings. Obviously, as part of the kind of the formal GAAP reporting out of our financial results, we compare to the prior year. But if you just compare our expense levels to last quarter, we’re seeing those drops already. Research and development in the second quarter was $22 million. We’ve dropped that to $17 million, so almost $5 million reduction in R&D there. SG&A costs were pretty flat, maybe $200,000 down. So our operating expenses quarter-over-quarter were reduced by about $5 million. So we are already experiencing those cost reductions and expect those to continue out and achieve that full $50 million in cost savings that we targeted when we announced our second quarter results.
Operator: Our next question comes from the line of Josh Jennings with TD Cowen.
Joshua Jennings: I was hoping that just — you guys have generated some strong supportive evidence for Symvess in the vascular trauma indication. And it sounds like this question has already been answered, but how impactful has that been just in terms of getting that processes started and then moving through the process? And just remind us, if you would, just how real-world outcomes are going to be tracked? Is there a post-approval registry study, and I think it will take some time for that to formulate. But when could we see any results from any registry — real-world registry outcomes?
Laura Niklason: Yes, Josh, those are good questions. Thank you. So the steady drumbeat of publications that have been coming out and frankly, are going to continue, has certainly been helpful in terms of providing additional assurance to surgeons as we speak to them at hospitals. Our initial endpoint for the V005 and V017 studies was at 30 days. And so, having these long-term outcomes that are now out in the public domain that we can share has been very powerful in terms of bringing surgeons on board. So — and again, we’re going to continue to lean into that. And your second question, I’m sorry.
Joshua Jennings: Just about the real-world outcomes and how those are being tracked and what’s the process there and…
Laura Niklason: Sure. So there is a post-approval study that we’ve agreed to with the FDA as part of our FDA approval in trauma since we’re a first-in-class product. So this will be a follow-up registry study in 100 trauma patients following at least 100 patients for at least a year. We have not kicked that trial off. In fact, we’re continuing discussions about the specifics of the trial design with the FDA. The FDA has been a little bit slower in part because of the shutdown and some other changes. And so, we’re still working through that. But we expect to kick off this post-marketing study sometime in the first half of 2026. And we expect data to come out from that 6 or 12 months after that. It certainly won’t be a full data set, but there will be some information forthcoming.
But frankly, I think that there will be more information forthcoming just from individual surgeon publications and reports on their experience, whether it’s case reports or short series. And some of that, we’re even going to see at the VEITH next week.
Joshua Jennings: Excellent. And I wanted to ask about Symvess in the AV access indication. Congratulations on the 2 results presented at ASN. In terms of the BLA process and this interim analysis, I mean, should we be thinking that if the interim analysis for the first 80 patients in V012 kind of those results mirror the 1 and 2 results in females from V007 that the package will be robust enough for the FDA to consider approval?
Laura Niklason: Yes, we believe so. I mean, the way we would approach this is that the LEAD study would be the study in women, the prospective head-to-head randomized study versus fistula in women. If we met our endpoint at the interim analysis, this would be a very strong indication of superiority of our vessel compared to the gold standard fistula in dialysis. So we would then lead with that publication and the V007 data, which includes data from all comers, as you know, but which has an important subgroup analysis in women and high-risk men, we anticipate that would be supporting data. So this would then be 2 prospective studies, basically, of course, pending the results of the V012 analysis, of course. But in that situation, we would have 2 prospective randomized studies supporting the same message in these patient subgroups.
Operator: Our next question comes from the line of Jason Kolbert with D. Boral Capital.
Jason Kolbert: Congrats on all the progress in transitioning to being a commercial entity. I’d like to just ask you a little bit about what’s involved in transitioning the sales force as you start looking towards hemodialysis and essentially the work you’re doing now kind of creating the awareness in the marketplace, how do you transition that into the commercial opportunity for dialysis?
Laura Niklason: Thank you, Jason. That’s a great question. So as your team probably knows, we’ve done the initial launch in trauma with a fairly small sales force, about 12 agents who are out in the field in different territories that are essentially high-value territories with large metropolitan areas and a lot of trauma centers. We are looking — as we’ve messaged to the market, we’re looking at strategically adding a small number of additional sales representatives in other geographies right now. We’re in the process of doing that. But again, as we’ve mentioned, there’s only about 3,000 vascular surgeons in the United States. And it’s — as we continue our sales efforts during 2025 and then through 2026, we anticipate having touch points with a large fraction of these surgeons.
The vascular surgeons who perform trauma operations are the same surgeons who also perform dialysis access operations. And so, the visibility with this surgeon cohort, we think is going to be tremendously supported by our trauma efforts in 2025 and 2026. That said, if the results in V012 are positive and if we file the supplemental BLA in the second half of 2026, we would aim for approval sometime in early 2027. And by that time, we would probably bring on an additional sales force. This would not be a huge sales force, and we haven’t given specific numbers, but there might be — I’m making this up. There might be another 10 or 20 reps because we would be targeting the same surgeons, but we would be targeting additional call points because dialysis access is primarily an outpatient procedure.
It’s the same surgeons, but it’s slightly different facilities.
Jason Kolbert: Yes, that makes a lot of sense. Can you talk also a little bit just because I’m fascinated by it, work you’re doing towards the virtual — well, the actual replacement of esophagus, trachea and the urinary conduit, how did those programs proceed? And how aware are you of all the prior data done by companies like Harvard Apparatus almost a decade ago?
Laura Niklason: Yes. So these other indications are indications that Humacyte has sought intellectual properties on and obtained intellectual property. I would say we do not have active preclinical programs advancing those indications right now. Frankly, we’re going to up-prioritize that as our revenues increase and as our cash position improves. But right now, we’re not doing active studies there. But, of course, from my long-standing work in this field, I’m very aware of the Harvard Apparatus outcomes and some of the problems that have occurred with esophagus and with airway replacements, very aware of those. Those are clinically challenging environments. And some of the earlier failures of other technologies, I believe, were driven by, frankly, a failure to consider the proper design criteria for the implant.
I would hope that as we continue to develop these products in the future that we would make better conduits. We would have — meet better design criteria, but we’ll have to see.
Operator: Our next question comes from the line of Bruce Jackson with The Benchmark Company.
Bruce Jackson: I wanted to follow-up on the NTAP submission. Have you reconsidered the strategy? And is there a plan to resubmit it?
Laura Niklason: Yes, Bruce, thank you for that. We’ve considered this carefully, and we’ve actually opted not to resubmit for the NTAP in trauma. The decision by CMS that our conduit in trauma is not novel was obviously very surprising for us as we messaged to the market last quarter. And in reviewing sort of their thinking that the CMS took a very reductionist approach to this and said, because we are a conduit that conducts blood, we are not novel because there are other conduits that conduct blood. We decided that it was probably not a good use of our resources to go back at that again. Instead, as you know, we have had some price reductions actually from around the time of the NTAP decision. And the reduction in price has helped to drive activity in the market. So we don’t really see the — we don’t see it as a good use of effort to reapproach NTAP at this time.
Dale Sander: Bruce, another consideration is that, out of the vascular trauma patients, only about 4% are covered by Medicare. So that was another consideration.
Bruce Jackson: The other question I had was around the — just some anecdotal information about the reorders and the marketing efforts. So in the multi-hospital approvals that you’ve gotten, have you seen additional hospitals ordered the product? And in the hospitals where you are selling right now, oftentimes, there’s a single surgeon who is your champion who does the initial implants. Have you seen any expansion beyond your initial implanting physicians?
Laura Niklason: We have. We have in a couple of the hospitals, I don’t want to name them specifically, but in a couple of trauma hospitals we have seen usage beyond our initial champion. As it is with any new surgical product, as you know, there’s typically a lead champion who will use and reuse. And then as his colleagues see those outcomes, they will continue to adopt. So we have seen that in several hospitals. As far as the hospital systems, when we get a VAC approval for a hospital system, there’s still individual contracting that we must do with each individual hospital. So while having a blanket VAC approval helps with an important step in that process, we are undergoing contract negotiations right now in multiple hospitals that are covered by some of these chains that we’ve gotten approvals in, if that makes sense.
Bruce Jackson: Yes, that does.
Operator: Our next question comes from the line of RK with H.C. Wainwright.
Swayampakula Ramakanth: Laura and Dale, congratulations. A couple of questions from me. The first one being, how do you initiate your conversations and maintain your conversations on value proposal to the folks on the VAC committees? And what are the things that resonate with them, especially when you had to still dislodge the autologous vein grafts? That’s question number one. And the second question, Dale, it looks like there’s some good operational excellence being done here. So you reduced your cash burn. Is this the new, I mean, cash use expectations from here onwards? And also with the $76 million in the bank now, how long of a runway are you going to have? And does that include the BLA submission for the dialysis indication?
Laura Niklason: So I’ll take the first question with regard to the value proposition to VACs and hospitals. As you know, RK, or you may remember, we published a Budget Impact Model in March of this year in the Journal of Medical Economics. That Budget Impact Model contemplated our initial list price of $29,500. And in that model, we showed that by virtue of decreasing amputations and conduit infection relative to plastic grafts, but also relative to other types of grafts like CryoVein and xenograft, because we decreased those complication costs, we actually came in cheaper even at our initial $29,500 price point. With the reduction in price point, that economic argument becomes even stronger. And so, when we lay that out to VACs, it is compelling.
What we see, though, is that, some hospitals are — there are — because of changes in Medicaid, I will say that there are some hospitals who are — despite the compelling Budget Impact Model, occasionally, hospitals will still look at just the initial acquisition price and say, even if it’s going to save us money in the longer term, I have to think about what I’m spending today. And so, there is still — in some hospitals, there is still some pushback. But the majority of cases — in the majority of our VAC submissions, those are now going through successfully. I think because these arguments around decreased cost of amputation, decreased cost of infection are really driving home, especially at our new price point.
Dale Sander: Yes. Regarding spend levels, I mean, obviously, quarter-over-quarter, we’ve reduced expenses quite a bit. I think both operating expenses and loss from operations have come down by about $5 million. Going out, I think we expect SG&A to be somewhat constant. I think we’ll continue to see some reductions in the R&D area. As will be further disclosed in our 10-Q filed probably later today, we expect that the cash on hand, based on how we expect to operate, takes us beyond 12 months from where we are today. And in terms of what milestones that means as part of your later question, we believe that takes us past having the interim results from our V012 study in dialysis. And based upon those results, taking us past the BLA filing in dialysis and also taking us past the commencement of human testing in a cardiac bypass graft surgery.
So it takes us past some — and there’ll be a lot else happening in the company also, but it certainly is sufficient to take us past some very key milestones.
Operator: Ladies and gentlemen, we’ve come to the end of our time allowed for questions. I’ll turn the floor back to Dr. Niklason for any final comments.
Laura Niklason: Thank you very much. We really appreciate the time that our investors and our analysts have taken to catch up with us on our call this quarter. We’ve continued to execute on the goals that we’ve said we would execute on. We’ve continued to expand our commercial launch, and we’re continuing to get traction in the clinical marketplace as surgeons continue to use our vessel in trauma. So we’re very excited with our progress, and we look forward to catching up with you again next quarter.
Operator: Thank you. This concludes today’s teleconference. You may disconnect your lines at this time. Thank you for your participation.
Follow Humacyte Inc. (NASDAQ:HUMA)
Follow Humacyte Inc. (NASDAQ:HUMA)
Receive real-time insider trading and news alerts


